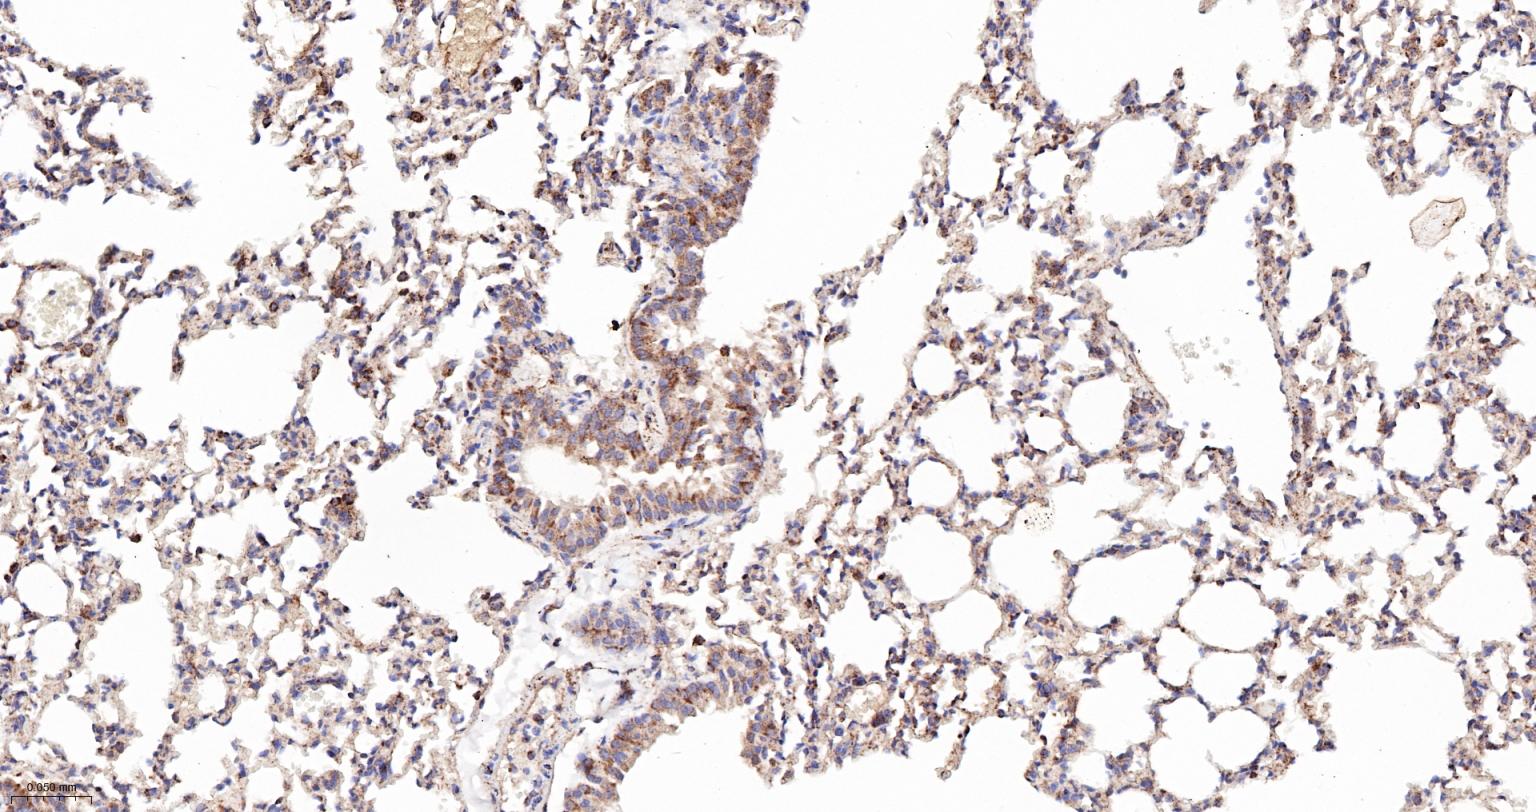
Bax抗体
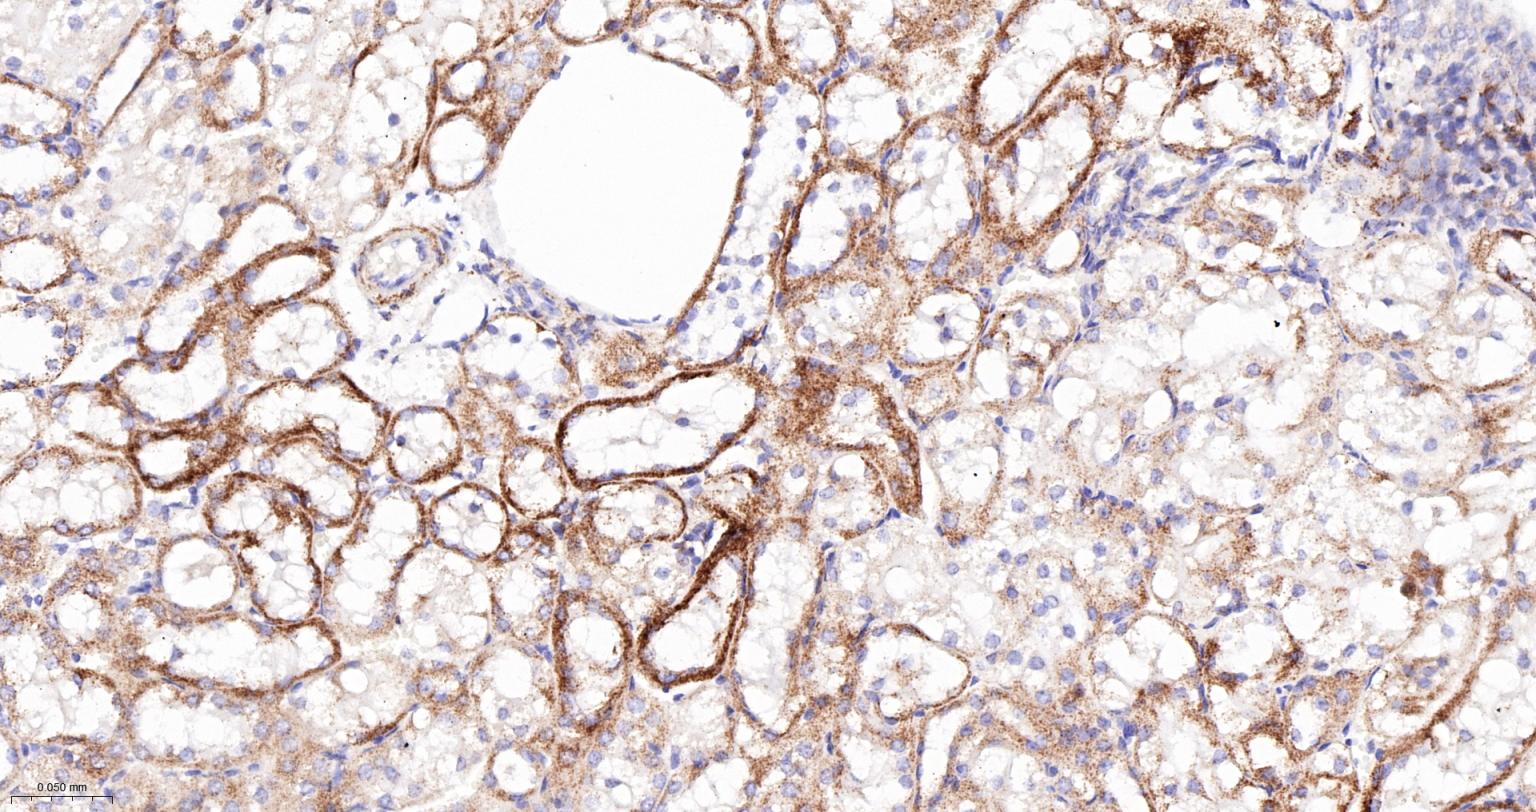
Bax抗体
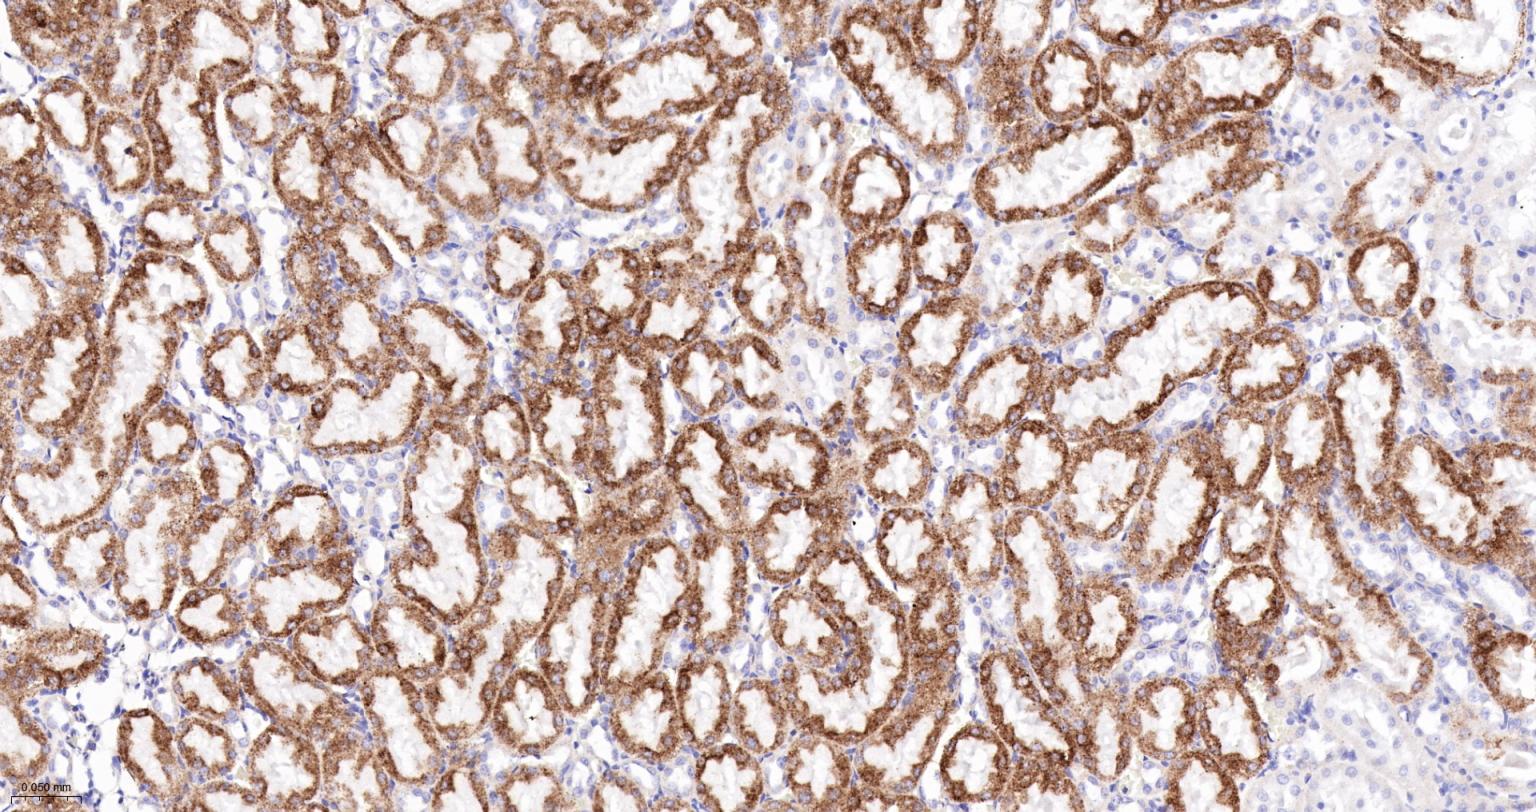
Bax抗体
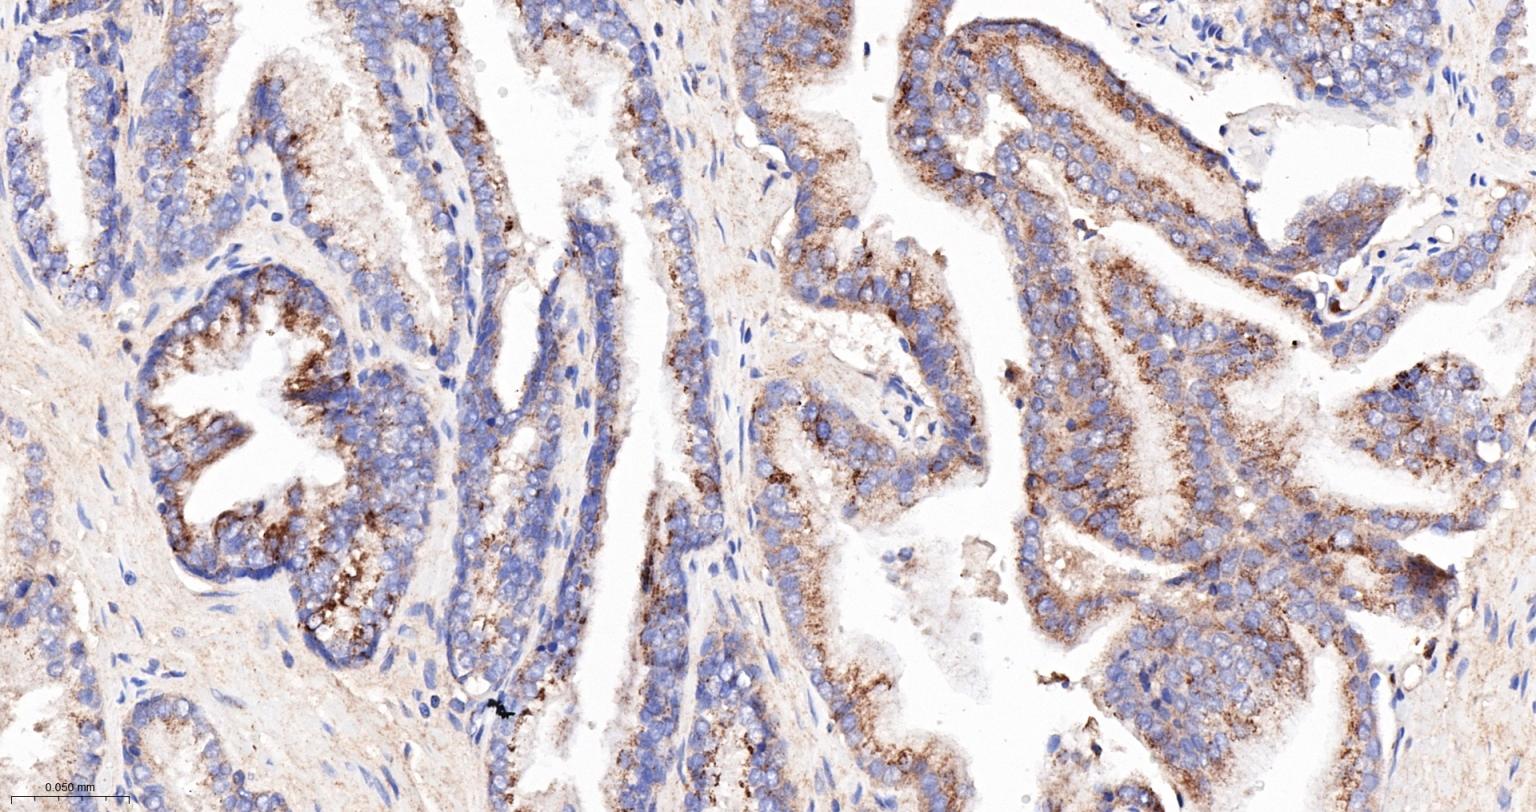
Bax抗体

Cancer > Cell Death > Apoptosis > Apoptosis Markers > Bcl 2 family
Cancer > Cell Death > Apoptosis > Metabolism
Cancer > Invasion/microenvironment > Apoptosis > Bcl 2 family
Cell Biology > Apoptosis > Intracellular > Associated Proteins
Cell Biology > Apoptosis > Intracellular > Bcl2 Family
Kits/ Lysates/ Other > Kits > ELISA Kits > ELISA Kits > Apoptosis marker and proteins ELISA kits
Metabolism > Pathways and Processes > Metabolism processes > Apoptosis

| 应用 | 已检合格种属 | 预测种属 | 推荐稀释比例 |
|---|---|---|---|
| IHC-P | Human, Mouse, Rat | 1:100-500 | |
| IHC-F | Human, Mouse, Rat | 1:100-500 | |
| IF | Human, Mouse, Rat | 1:100-500 |
交叉反应: Human, Mouse, Rat
暂无相关产品